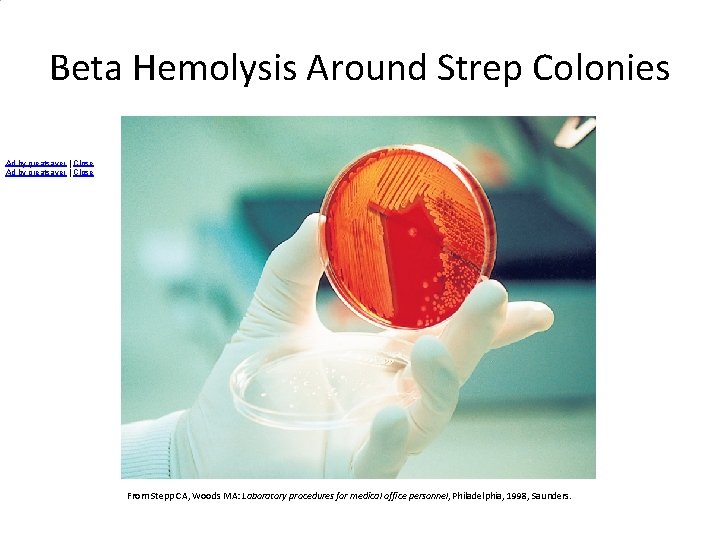
Beta Hemolysis Around Strep Colonies Ad by greatsaver | Close From Stepp CA, Woods
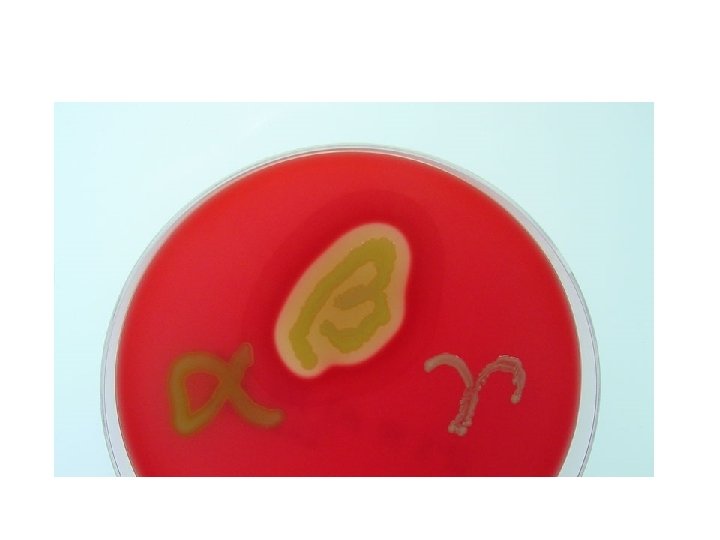
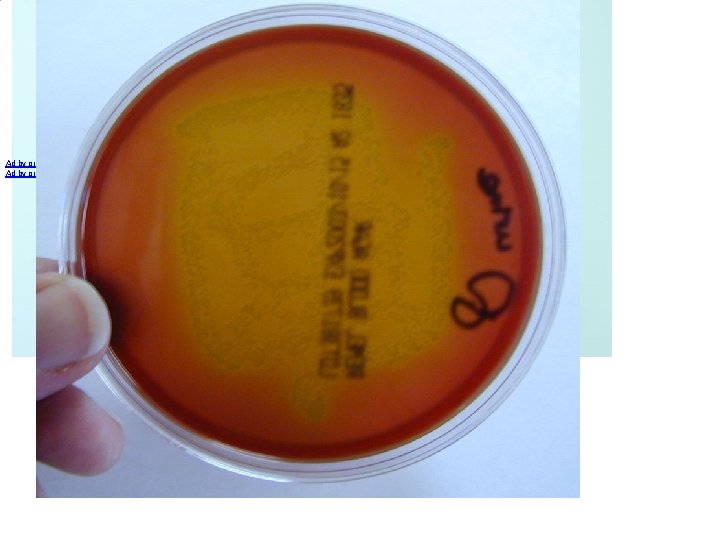
Ad by greatsaver | Close

Gram pos cocci Staphylococci and Streptococci And anaerobic

Gram pos cocci Staphylococci and Streptococci And anaerobic cocci

Gram-positive bacteria are those that are stained dark blue or violet by Gram staining. This is in contrast to gram-negative bacteria, which appear red b/cs cannot retain the crystal violet stain, instead taking up the counterstain (safranin or fuchsin) and appearing red or pink. Gram-positive organisms are able to retain the crystal violet stain because of the thick peptidoglycan layer. Grampositive bacteria have a thick peptidoglycan layer, which is superficial to the cell membrane. This is in contrast to Gram-negative bacteria, which may have a thin peptidoglycan layer that is located between two cell membranes.

Bacterial Shapes

• The staphylococci are gram-positive spherical cells, usually arranged in grape-like irregular clusters.

• The genus Staphylococcus has at least 35 species. The three main species of clinical importance are Staphylococcus aureus, Staphylococcus epidermidis, and Staphylococcus saprophyticus. • Staphylococcus aureus is coagulase-positive, which differentiates it from the other species. • S aureus is a major pathogen for humans

Typical Organisms morphology • Staphylococci are spherical cells about 1 um in diameter arranged in irregular clusters • Single cocci, pairs, tetrads, and chains are also seen in liquid cultures. • Young cocci stain strongly gram-positive; on aging, many cells become gram-negative. Staphylococci are non-motile and do not form spores.

Gram positive cocci & Gram negative rods compared

Clinical Findings A localized staphylococcal infection appears as a "pimple, " hair follicle infection, or abscess. Wound, eg, postoperative staphylococcal wound infection or infection following trauma. S aureus disseminates and bacteremia ensues, endocarditis, acute hematogenous osteomyelitis, meningitis, or pulmonary infection can result.

• An abscess (Latin: abscessus) is a collection of pus that has built up within the tissue of the body

• Food poisoning due to staphylococcal enterotoxin is characterized by a short incubation period (1– 8 hours); • violent nausea, vomiting, and diarrhea; and rapid convalescence. • Toxic shock syndrome is manifested by an abrupt onset of high fever, vomiting, diarrhea, myalgias(muscle pain), a scarlatiniform rash, and hypotension with cardiac and renal failure in the most severe cases. • It often occurs within 5 days after the onset of menses in young women who use tampons, but it also occurs in children or in men with staphylococcal wound infections

Enzymes • The organisms produce enzymes and toxins • Catalase-Staphylococci produce catalase • Coagulase and Clumping Factor-S aureus produces coagulase, an enzyme-like protein that clots oxalated or citrated plasma.

• Coagulase binds to prothrombin; initiate fibrin polymerization an invasive potential.

• Clumping factor is a surface S. aureus compound that is responsible for adherence of the organisms to fibrinogen and fibrin. • Exotoxins • The a-toxin is a potent hemolysis • The b-toxin degrades sphingomyelin of cells

• Leukocidin • This toxin of S aureus has two components. It can kill white blood cells of humans and rabbits • Exfoliative Toxins +Toxic Shock Syndrome Toxin • The 2 act synergistically.

Toxic Shock Syndrome Toxin • Most S aureus strains isolated from patients with toxic shock syndrome produce a toxin called toxic shock syndrome toxin-1 (TSST-1), which is the same as enterotoxin F. TSST-1 is the prototypical superantigen. TSST-1 binds to MHC class II molecules, yielding T cell stimulation, which promotes the protean manifestations of the toxic shock syndrome. The toxin is associated with fever, shock, and multisystem involvement, including a desquamative skin rash. The gene for TSST-1 is found in about 20% of S aureus isolates

Enterotoxins • There are multiple enterotoxins (A–E, G–I, K– M). • Like TSST-1, the enterotoxins are superantigens. The enterotoxins are heatstable and resistant to the action of gut enzymes. • Are important cause of food poisoning so are enterotoxins

Diagnostic Laboratory Tests • Specimens • Surface swab pus, blood, tracheal aspirate, or spinal fluid for culture, depending upon the localization of the process. • Smears • Typical staphylococci appear as gram positive cocci in clusters in Gram-stained smears of pus or sputum. It is not possible to distinguish saprophytic (S epidermidis) from pathogenic (S aureus) organisms on smears.

Culture • Specimens inoculated (planted) on blood agar plates give rise to typical colonies in 18 hours at 37 °C, but haemolysis and pigment production may not occur until several days later and are optimal at room temperature. • S aureus but not other staphylococci ferment mannitol. • Mixed flora can be cultured on media containing 7. 5% Na. Cl; the salt inhibits most other normal flora but not S. aureus--- Mannitol salt.

• Culture • Specimens contaminated with a mixed flora can be cultured on media containing 7. 5% Na. Cl; the salt inhibits most other normal flora but not S aureus. Mannitol salt agar or commercially available chromogenic media are used to screen for nasal carriers of S aureus and patients with cystic fibrosis.

Catalase Test • A drop of 3% hydrogen peroxide solution is placed on a slide, and a small amount of the bacterial growth is placed in the solution. • The formation of bubbles (the release of oxygen) indicates a positive test. • Staphylocci are catalase positive and streptococci is negative

Coagulase Test • Citrated rabbit (or human) plasma diluted 1: 4 is mixed with an e 6 gm ; qual volume of broth culture or growth from colonies on agar and incubated at 37 °C. • A tube of plasma mixed with sterile broth is included as a control. If clots form in 1– 4 hours, the test is positive. • Coagulase-positive staphylococci are considered pathogenic for humans


Flowchart 1: Basic Biochemical Tests for Differentiating Gram-Positive Cocci Gram (+) cocci (+) Catalase (-) Streptococci Staphylococci (+) Coagulase MSA S. aureus (-) Hemolysis (BAP) s. albus Alpha Gamma Novo + S. epidermidis Esculin (+) Na. Cl (+) Enterococci Esculin (+) Na. Cl (-) Group D Non. Enterococci Esculin (+) Na. Cl (+) Esculin (-) Na. Cl (-) Taxo P sensitive Enterococci Beta S. pneumoniae Group D Non. Enterococci Taxo A Sensitive Group A S. pyogenes (+) Group B S. agalactiae Esculin (+) Na. Cl (-) Resistant CAMP Test Esculin (+) Na. Cl (+) Enterococci (-) Esculin (+) Na. Cl (-) Group D Non. Enterococci

• xt Books The HELP_ME! Gram positive coccus Flow Determination Chart Last update 7. 2013


The Streptococci: The streptococci are gram-positive spherical bacteria that characteristically form pairs or chains during growth. They are widely distributed in nature. Some are members of the normal human flora; others are associated with important human diseases attributable in part to infection by streptococci, in part to sensitization to them. Streptococci elaborate a variety of extracellular substances and enzymes

Classification of Streptococci The classification of streptococci into major categories has been based on: (1) colony morphology and hemolytic reactions on blood agar; (2) serologic specificity of the cell wall groupspecific substance and other cell wall or capsular antigens; (3) biochemical reactions and resistance to physical and chemical factors; and (4) ecologic features. Molecular genetics have also been used to study the streptococci

name Streptococcus pyogenes Strept classification group A Streptococcus agalactiae B Streptococcus dysgalactiae subspecies equisimilis; others C, G Enterococcus faecalis (and other enterococci Streptococcus bovis (non-enterococcus) D D Streptococcus anginosus group (S anginosus, S F, A, C, G, (untypable) intermedius, S constellatus, S milleri group) Viridans streptococci (many species Streptococcus pneumoniae Peptostreptococcus (many species) Usually not typed or untypable none None

Haemolysis • Many streptococci are able to haemolyze red blood cells in-vitro in varying degrees. Complete disruption of erythrocytes with clearing of the blood around the bacterial growth is called β-haemolysis. Incomplete lysis of erythrocytes with reduction of hemoglobin and the formation of green pigment is called α-haemolysis. Other streptococci are non-hemolytic (sometimes called gamma hemolysis
Beta Hemolysis Around Strep Colonies Ad by greatsaver | Close From Stepp CA, Woods MA: Laboratory procedures for medical office personnel, Philadelphia, 1998, Saunders.

Ad by greatsaver | Close


Gram positive cocci in chains

Group-Specific Substance (Lancefield Classification) • Carbohydrates contained in the cell wall of many streptococci form the basis of serologic grouping into Lancefield groups A–H and K–U.

• The serologic specificity of the group-specific carbohydrate is determined by an amino sugar. • For group A streptococci, ---rhamnose-Nacetylglucosamine; • for group B, ---rhamnose-glucosamine polysaccharide; • for group C, it is rhamnose-N-cetylgalactosamine; • for group D, it is glycerol teichoic acid, D-alanine and glucose; • and • for group F, it is glucopyranosyl-N-acetylgalactosamine

Capsular Polysaccharides • The antigenic specificity of the capsular polysaccharides is used to classify S pneumoniae into over 90 types and to type the group B streptococci (S. agalactiae).

Biochemical Reactions Biochemical tests are most often used to classify streptococci after the colony growth and hemolytic characteristics have been observed. Biochemical tests are used for species that typically do not react with the commonly used antibody preparations for the group-specific substances, groups A, B, C, F, and G.

Antigenic Structure • M Protein--This substance is a major virulence factor of group A (S pyogenes) • T Substance--This antigen has no relationship to virulence of streptococci. • Nucleoproteins--P substances in cellwall

Toxins & Enzymes • More than 20 extracellular • Streptokinase (Fibrinolysin)--produced by many strains of group A -hemolytic streptococci • Streptodornase--(streptococcal deoxyribonuclease) depolymerizes DNA. • Hyaluronidase--splits hyaluronic acid, a ground substance of connective tissue.

Erythrogenic toxin • Pyrogenic Exotoxins (Erythrogenic Toxin) • Pyrogenic exotoxins are elaborated by S pyogenes. • There are three antigenically distinct streptococcal pyrogenic exotoxins: A, B, and C. • They are associated with streptococcal toxic shock syndrome and scarlet fever

Diphosphopyridine Nucleotidase • This enzyme is elaborated into the environment by some streptococci, has ability to kill leukocytes.

Haemolysins • The -hemolytic group A S pyogenes elaborates two haemolysins (streptolysins). • Streptolysin O is a protein (MW 60, 000) that is haemolytically active in the reduced state but rapidly inactivated in the presence of oxygen • Streptolysin O is responsible for some of the haemolysis seen when grown on BA

Diseases Attributable to Invasion by S pyogenes • Β-Haemolytic Group A Streptococci • The portal of entry determines the principal clinical picture. • Erysipelas- • If the portal of entry is the skin, erysipelas results, with massive brawny oedema and a rapidly advancing margin of infection.

• Cellulitis • Streptococcal cellulitis is an acute, rapidly spreading infection of the skin and subcutaneous tissues. • It follows infection associated with mild trauma, burns, wounds, or surgical incisions. Pain, tenderness, swelling, and erythema occur.

Necrotizing Fasciitis (Streptococcal Gangrene • This is infection of the subcutaneous tissues and fascia. There is extensive and very rapidly spreading necrosis of the skin and subcutaneous tissues. • Bacteria other than S pyogenes can also cause necrotizing fasciitis. The group A streptococci that cause necrotizing fasciitis have sometimes been termed "flesh-eating bacteria”

• Puerperal Fever • If the streptococci enter the uterus after delivery, puerperal fever develops, which is essentially a septicemia originating in the infected wound (endometritis)

• Bacteremia/Sepsis • Infection of traumatic or surgical wounds with streptococci results in bacteremia, which rapidly can be fatal. • S. pyogenes bacteremia can also follow skin infections, such as cellulitis and rarely pharyngitis.

• Streptococcal Sore Throat • The most common infection due to βhaemolytic S. pyogenes is streptococcal sore throat or pharyngitis • Streptococcal Pyoderma • Local infection of superficial layers of skin, especially in children, is also called impetigo

• Fulminant, invasive S pyogenes infections with streptococcal toxic shock syndrome are characterized by shock, bacteremia, respiratory failure, and multiorgan failure

Non sapurative infections • Acute Glomerulonephritis • This sometimes develops 3 weeks after S pyogenes skin infection (pyoderma, impetigo). • Glomerulonephritis may be initiated by antigen-antibody complexes on the glomerular basement membrane.

• Rheumatic Fever • This is the most serious sequela of S pyogenes because it results in damage to heart muscle and valves. Certain strains of group A streptococci contain cell membrane antigens that cross-react with human heart tissue antigens.

Diagnostic Laboratory Tests • Specimens to be obtained depend upon the nature of the streptococcal infection. eg • throat swab, • pus, • or blood is obtained for culture. • Serum is obtained for antibody determinations. • Smears--Smears from pus often show single cocci or pairs rather than definite chains.

• Culture • Specimens suspected of containing streptococci are cultured on blood agar plates in CO 2 jars • Look for the type of haemolysis

Serologic Tests • A rise in the titer of antibodies to many group A streptococcal antigens can be estimated. Such antibodies include antistreptolysin O (ASO), particularly in respiratory disease; • anti-DNase and antihyaluronidase, particularly in skin infections; antistreptokinase; anti-M type-specific antibodies; and others. Of these, the anti-ASO titer is most widely used test.

Streptococcus agalactiae • These are the group B streptococci. They typically are β-hemolytic. Group B streptococci are part of the normal vaginal flora in 5– 25% of women. Group B streptococcal infection during the first month of life may present as fulminant sepsis(secer and sudden onset), meningitis, or respiratory distress syndrome. Intravenous ampicillin given to mothers, who carry group B streptococci and are in labor, prevents colonization of their infants and group B streptococcal disease.

Viridans Streptococci • The viridans streptococci include S mitis, S mutans, S salivarius, S sanguis, and others. Typically they are α-hemolytic, but they may be nonhemolytic. • Their growth is not inhibited by Optochin, and colonies are not soluble in bile (deoxycholate).

• In bacteremia, viridans streptococci, pneumococci, or enterococci may settle on normal or previously deformed heart valves, producing acute endocarditis. • Rapid destruction of the valves frequently leads to fatal cardiac failure in days or weeks unless a prosthesis is inserted.

• Streptococcus pneumoniae • The pneumococci (S pneumoniae) are grampositive diplococci, often lancet-shaped or arranged in chains, possessing a capsule of polysaccharide that permits typing with specific antisera. • Pneumococci are normal inhabitants of the upper respiratory tract of 5– 40% of humans and can cause pneumonia, sinusitis, otitis(ear), bronchitis, bacteremia, meningitis, and other infectious processes.

• Culture • Pneumococci form small round colonies, at first dome-shaped and later developing a central plateau with an elevated rim. Pneumococci are α-hemolytic on blood agar. Growth is enhanced by 5– 10% CO 2.

Clinical Findings • The onset of pneumococcal pneumonia is usually sudden, with fever, chills, and sharp pleural pain.

• Diagnostic Laboratory Tests • Blood, CSF and sputum are collected for demonstration of pneumococci by smear and culture. • Stained Smears • A Gram-stained film of rusty-red sputum shows typical organisms, many polymorphonuclear neutrophils, and many red cells. • Capsule Swelling Tests(the quellung reaction) • Fresh emulsified sputum mixed with antiserum causes capsule swelling (the quellung reaction) for identification of pneumococci.

• Culture Sputum or CSF or blood on Blood agar and incubated in CO 2 or a candle jar. • After growth subculture on BA , place optochin on it.

Enterococci • The enterococci have the group D groupspecific substance and were previously classified as group D streptococci. • They are part of the normal enteric flora. • They are usually non-haemolytic, but occasionally –haemolytic.

• Enterococci may cause meningitis and bacteremia in neonates. • In adults, enterococci can cause endocarditis. In intra-abdominal, wound, urine, and other infections, enterococci are cultured along with other species of bacteria.
- Slides: 65